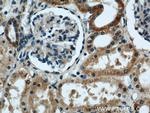
EYA1 Antibody in Immunohistochemistry (Paraffin) (IHC (P))

Search
Proteintech
EYA1 Polyclonal Antibody
{{$productOrderCtrl.translations['antibody.pdp.commerceCard.promotion.promotions']}}
{{$productOrderCtrl.translations['antibody.pdp.commerceCard.promotion.viewpromo']}}
{{$productOrderCtrl.translations['antibody.pdp.commerceCard.promotion.promocode']}}: {{promo.promoCode}} {{promo.promoTitle}} {{promo.promoDescription}}. {{$productOrderCtrl.translations['antibody.pdp.commerceCard.promotion.learnmore']}}
产品信息
22658-1-AP
种属反应
已发表种属
宿主/亚型
分类
类型
抗原
偶联物
形式
浓度
规格
纯化类型
保存液
内含物
保存条件
运输条件
产品详细信息
Immunogen sequence: MEMQDLTSP HSRLSGSSES PSGPKLGNSH INSNSMTPNG TEVKTEPMSS SETASTTADG SLNNFSGSAI GSSSFSPRPT HQFSPPQIYP SNRPYPHILP TPSSQTMAAY GQTQFTTGMQ QATAYATYPQ PGQPYGISSY GALWAGIKTE GGLSQSQSPG QTGFLSYGTS FSTPQPGQAP YSYQMQGSSF TTSSGIYTGN NSLTNSSGFN SSQQDYPSYP SFGQGQYAQY YNSSPYPAHY MTSSNTSPTT PSTNATYQLQ EPPSGITSQA VTDPTAEYST IHSPSTPIKD SDSDRLRRGS D (1-300 aa encoded by BC121799)
靶标信息
This gene encodes a member of the eyes absent family of proteins. The encoded protein may play a role in the developing kidney, branchial arches, eye, and ear. Mutations of this gene have been associated with branchiootorenal dysplasia syndrome, branchiootic syndrome, and sporadic cases of congenital cataracts and ocular anterior segment anomalies. A similar protein in mice can act as a transcriptional activator. Four transcript variants encoding three distinct isoforms have been identified for this gene.
仅用于科研。不用于诊断过程。未经明确授权不得转售。
生物信息学
蛋白别名: EYA1B; EYA1C; Eyes absent; Eyes absent homolog 1; MGC141875; OTTHUMP00000195053; Protein phosphatase EYA1; unnamed protein product
基因别名: BOP; BOR; BOS1; EYA1; OFC1; OTFCS
UniProt ID: (Human) Q99502, (Mouse) P97767
Entrez Gene ID: (Human) 2138, (Mouse) 14048